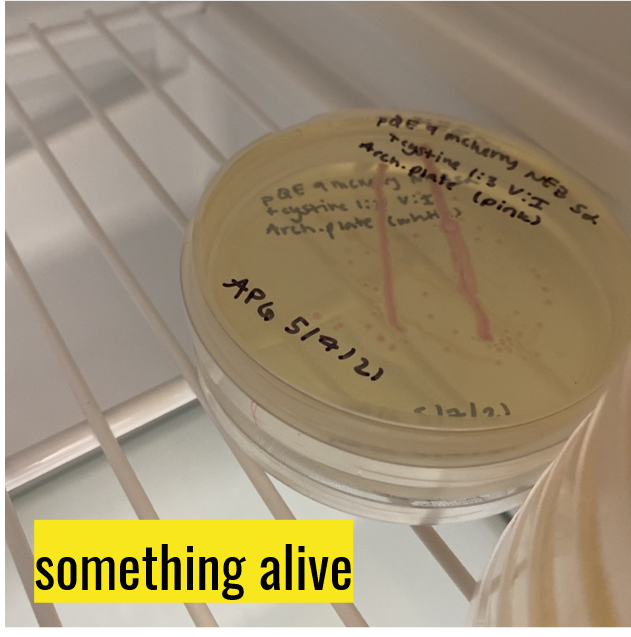
2021-Spring1.png

News — 2021
Louis passed his MSE qualifying exam! Congratulations!!
Prof. Mai received an award from the 2022 Air Force Office of Scientific Research Young Investigator Program (AFOSR YIP)! Thank you for supporting our work toward engineering biomolecular actuators from ion-responsive repeat proteins!
We welcome new postdoctoral scholar Mike Burroughs to the lab! Mike joins us from the Helgeson and Leal groups at UC Santa Barbara. He will investigate biolubrication at the single-molecule level and collaborate with the Congreve and Xia labs to develop recyclable 3D printing resins.
A new academic year is upon us as we welcome new students to campus and Brendan Wirtz to our group as a new ChemE Ph.D. rotation student!
A huge THANK YOU to Christopher + Ankush for their hard work and fantastic contributions this summer!! Christopher brought our OpenTrons robot "Otto" online, and Ankush developed new codes for single-molecule image analysis. We're especially grateful for support from the ChemE REU Program (Stanford VPUE) and for mentorship by Marina and Louis!
Congratulations to Winnie, who is embarking on a summer REU with the Soft Materials and Interfaces Group at the University of Kentucky! We’re excited to learn more about Winnie’s summer research when she returns to campus this fall.
We are excited to share a few snapshots from our spring social, which included a socially distanced photo scavenger hunt! We also welcomed our newest group members, Ta-Chung Liu (Postdoc from the Taiwan LEAP@Stanford program) and Alana Gudinas (Physics PhD student) and met Ankush Dhawan, who will join us for a summer ‘21 REU along with Christopher Latham. Welcome to the team!!
Our brackets are all busted, but congratulations to Winnie for winning the inaugural Mai March Madness bracket challenge! Winnie’s desk is the new home for the Golden Picker Award, until next year… (Interested in how we made the trophy? Check it out here!)
We are excited that the group is growing! Welcome to Natasha Jagnandan (Chemical Engineering PhD student) and Alana Gudinas (Physics PhD rotation student)!
Danielle was selected as the 2021 DPOLY representative for the American Physical Society DPOLY/UKPPG Lecture Exchange. We look forward to the Physical Aspects of Polymer Science Meeting at the Institute of Physics in London!
Welcome to our newest group member, Louis Wang!! Louis joins us from the Department of Materials Science and Engineering.
Danielle gave an invited talk at the (remote) 86th New England Complex Fluids Meeting. Thanks for the kind invitation!
Danielle shared her science story on the podcast “How Science Happens”, hosted by Profs. Wally Paxton, DJ Seo, and Doug Tree. Listen here!